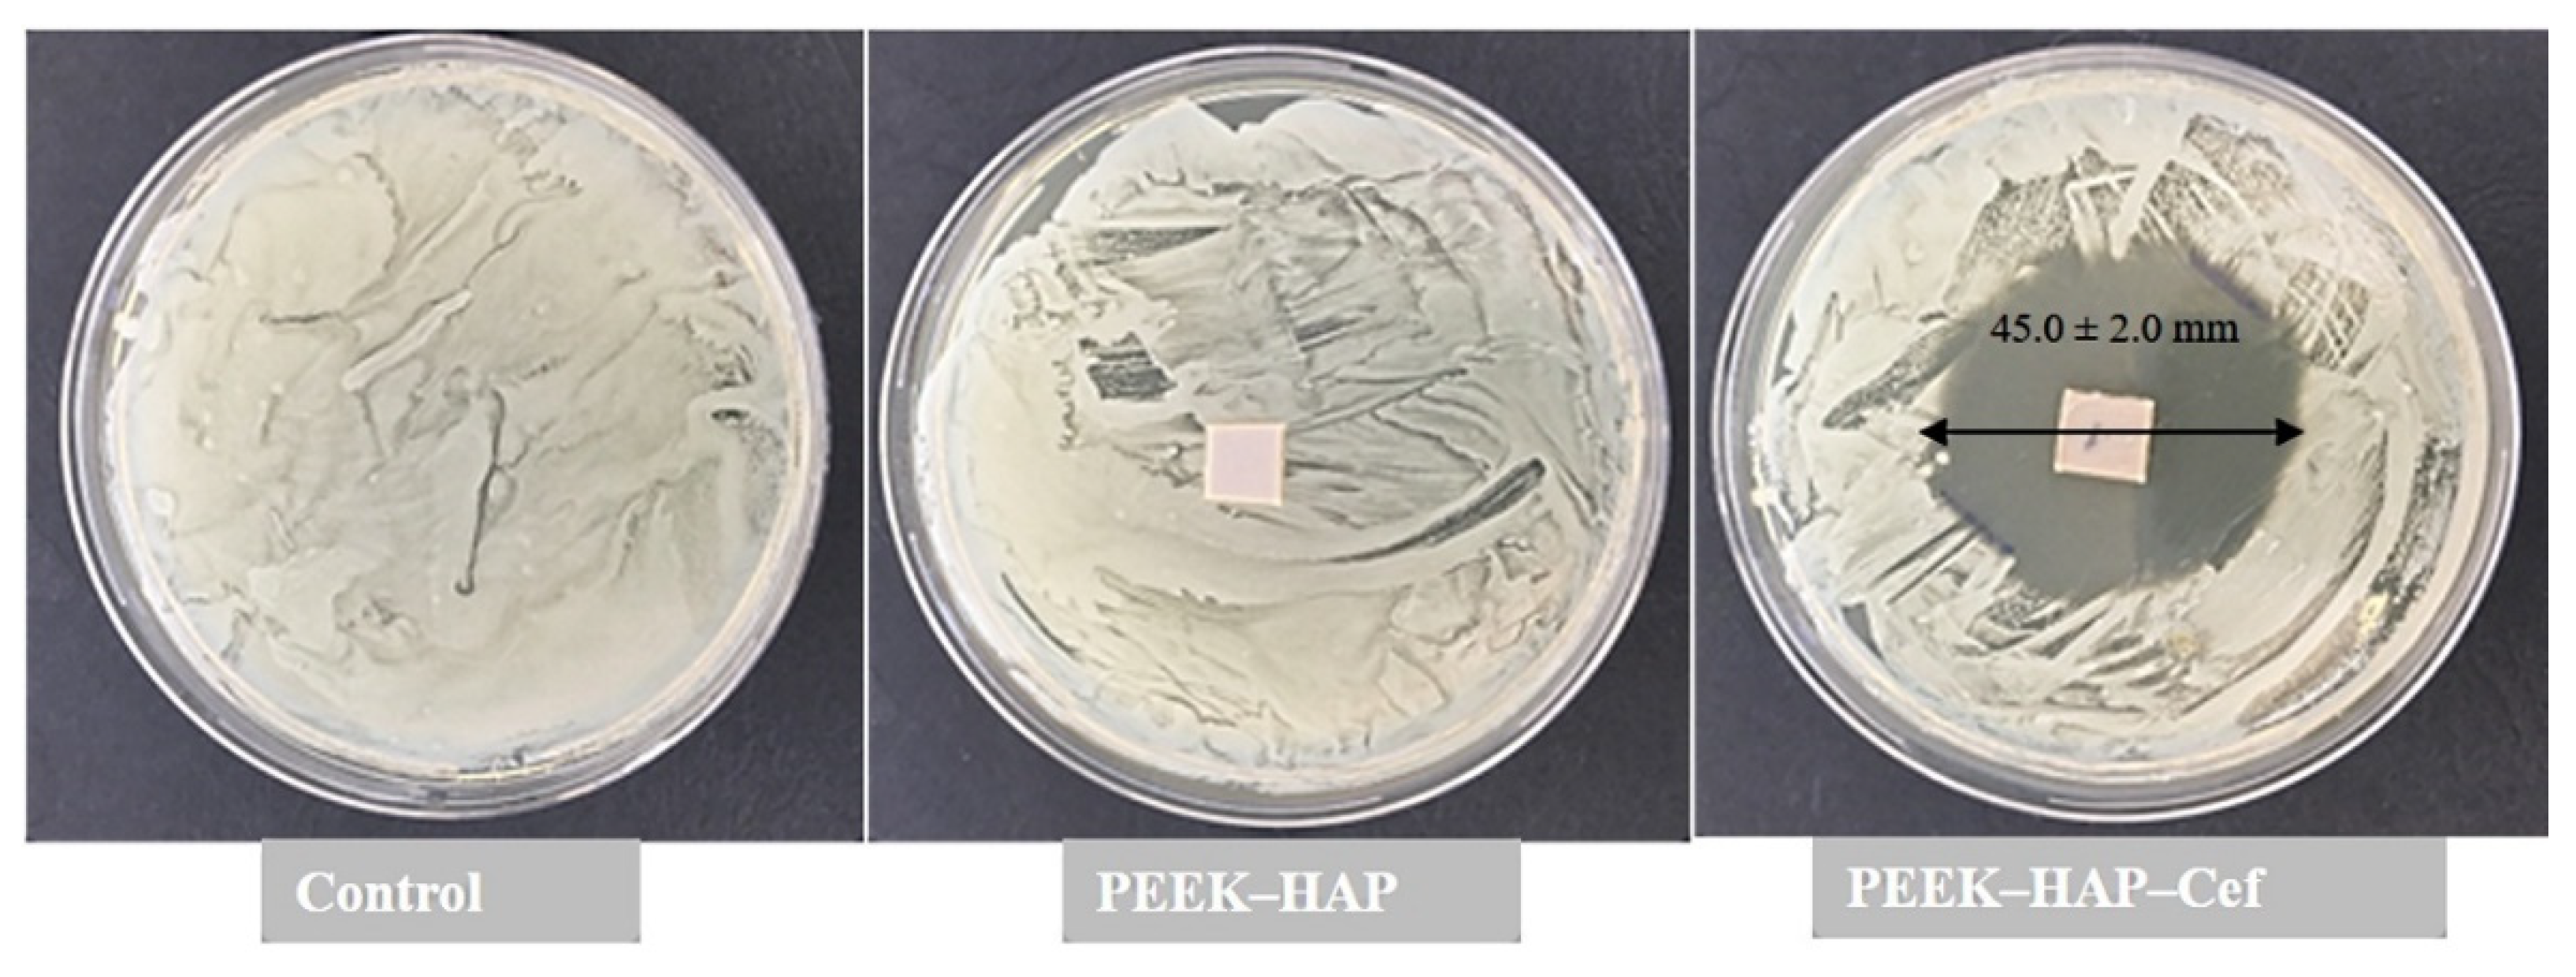
Nanomaterials 11 01690 g008 Nanomaterials 11 01690 g008

Drug-Releasing Antibacterial Coating Made from Nano-Hydroxyapatite Using the Sonocoating Method
Abstract
1. Introduction
2. Materials and Methods
2.1. Synthesis of nanoHAP Solutions for Coating
2.2. Sonocoating of PEEK Implants
2.3. Incorporating the Antibacterial Drug in Sonocoated nanoHAP
2.4. Determination of the Amount of Loaded Drug
2.5. In Vitro Drug Release Study
2.6. Characterization Techniques
2.7. Assessment of Antimicrobial Activity
2.8. Statistical Analysis
3. Results and Discussion
3.1. Microscopic Characterization
3.2. Contact Angle Measurement of Coatings
3.3. AFM Analysis
3.4. FTIR Characterization
3.5. Drug Loading and In Vitro Release
3.6. Antibacterial Evaluations
4. Conclusions
Author Contributions
Funding
Acknowledgments
Conflicts of Interest
References
- Gunputh, U.; Le, H. 6Composite coatings for implants and tissue engineering scaffolds. In Biomedical Composites, 2nd ed.; Ambrosio, L., Ed.; Woodhead Publishing: Sawston, UK, 2017; pp. 111–138. [Google Scholar]
- Wang, M.; Tang, T. Surface treatment strategies to combat implant-related infection from the beginning. J. Orthop. Transl. 2019, 17, 42–54. [Google Scholar] [CrossRef]
- Mangram, A.J.; Horan, T.C.; Pearson, M.L.; Silver, L.C.; Jarvis, W.R.; Hospital Infection Control Practices Advisory Committee. Guideline for prevention of surgical site infection. Infect. Control Hosp. Epidemiol. 1999, 20, 250–278. [Google Scholar] [CrossRef] [PubMed]
- Darouiche, R.O. Treatment of Infections Associated with Surgical Implants. N. Engl. J. Med. 2004, 350, 1422–1429. [Google Scholar] [CrossRef] [PubMed]
- Oliveira, M.; Nunes, S.F.; Carneiro, C.; Bexiga, R.; Bernardo, F.; Vilela, C.L. Time course of biofilm formation by Staphylococcus aureus and Staphylococcus epidermidis mastitis isolates. Vet. Microbiol. 2007, 124, 187–191. [Google Scholar] [CrossRef] [PubMed]
- Zilberman, M.; Elsner, J.J. Antibiotic-eluting medical devices for various applications. J. Control. Release 2008, 130, 202–215. [Google Scholar] [CrossRef] [PubMed]
- Bazaka, K.; Jacob, M.V.; Crawford, R.J.; Ivanova, E.P. Efficient surface modification of biomaterial to prevent biofilm formation and the attachment of microorganisms. Appl. Microbiol. Biotechnol. 2012, 95, 299–311. [Google Scholar] [CrossRef] [PubMed]
- Boase, N.R.B.; Torres, M.D.T.; Fletcher, N.L.; de la Fuente-Nunez, C.; Fairfull-Smith, K.E. Polynitroxide copolymers to reduce biofilm fouling on surfaces. Polym. Chem. 2018, 9, 5308–5318. [Google Scholar] [CrossRef]
- Guilhen, C.; Forestier, C.; Balestrino, D. Biofilm dispersal: Multiple elaborate strategies for dissemination of bacteria with unique properties. Mol. Microbiol. 2017, 105, 188–210. [Google Scholar] [CrossRef]
- Narayana, S.V.V.S.P.; Srihari, S.V.V.P. A Review on Surface Modifications and Coatings on Implants to Prevent Biofilm. Regen. Eng. Transl. Med. 2019. [Google Scholar] [CrossRef]
- Bruellhoff, K.; Fiedler, J.; MöLler, M.; Groll, J.; Brenner, R.E. Surface Coating Strategies to Prevent Biofilm Formation on Implant Surfaces. Int. J. Artif. Organs 2010, 33, 646–653. [Google Scholar] [CrossRef]
- Cloutier, M.; Mantovani, D.; Rosei, F. Antibacterial Coatings: Challenges, Perspectives, and Opportunities. Trends Biotechnol. 2015, 33, 637–652. [Google Scholar] [CrossRef]
- Pan, C.; Zhou, Z.; Yu, X. Coatings as the useful drug delivery system for the prevention of implant-related infections. J. Orthop. Surg. Res. 2018, 13, 220. [Google Scholar] [CrossRef]
- Higuchi, J.; Fortunato, G.; Wozniak, B.; Chodara, A.; Domaschke, S.; Meczynska-Wielgosz, S.; Kruszewski, M.; Dommann, A.; Lojkowski, W. Polymer Membranes Sonocoated and Electrosprayed with Nano-Hydroxyapatite for Periodontal Tissues Regeneration. Nanomaterials 2019, 9, 1625. [Google Scholar] [CrossRef]
- Smolen, D.; Chudoba, T.; Malka, I.; Kedzierska, A.; Lojkowski, W.; Swieszkowski, W.; Kurzydlowski, K.J.; Kolodziejczyk-Mierzynska, M.; Lewandowska-Szumiel, M. Highly biocompatible, nanocrystalline hydroxyapatite synthesized in a solvothermal process driven by high energy density microwave radiation. Int. J. Nanomed. 2013, 8, 653–668. [Google Scholar] [CrossRef]
- Rogowska-Tylman, J.; Locs, J.; Salma, I.; Woźniak, B.; Pilmane, M.; Zalite, V.; Wojnarowicz, J.; Kędzierska-Sar, A.; Chudoba, T.; Szlązak, K.; et al. In vivo and in vitro study of a novel nanohydroxyapatite sonocoated scaffolds for enhanced bone regeneration. Mater. Sci. Eng. C 2019, 99, 669–684. [Google Scholar] [CrossRef] [PubMed]
- Stigter, M.; Bezemer, J.; de Groot, K.; Layrolle, P. Incorporation of different antibiotics into carbonated hydroxyapatite coatings on titanium implants, release and antibiotic efficacy. J. Control. Release 2004, 99, 127–137. [Google Scholar] [CrossRef] [PubMed]
- Geuli, O.; Metoki, N.; Zada, T.; Reches, M.; Eliaz, N.; Mandler, D. Synthesis, coating, and drug-release of hydroxyapatite nanoparticles loaded with antibiotics. J. Mater. Chem. B 2017, 5, 7819–7830. [Google Scholar] [CrossRef]
- Huang, D.; Zuo, Y.; Zou, Q.; Zhang, L.; Li, J.; Cheng, L.; Shen, J.; Li, Y. Antibacterial Chitosan Coating on Nano-hydroxyapatite/Polyamide66 Porous Bone Scaffold for Drug Delivery. J. Biomater. Sci. Polym. Ed. 2011, 22, 931–944. [Google Scholar] [CrossRef] [PubMed]
- Prasanna, A.P.S.; Venkatasubbu, G.D. Sustained release of amoxicillin from hydroxyapatite nanocomposite for bone infections. Prog. Biomater. 2018, 7, 289–296. [Google Scholar] [CrossRef]
- Johansson, P.; Jimbo, R.; Kozai, Y.; Sakurai, T.; Kjellin, P.; Currie, F.; Wennerberg, A. Nanosized Hydroxyapatite Coating on PEEK Implants Enhances Early Bone Formation: A Histological and Three-Dimensional Investigation in Rabbit Bone. Materials 2015, 8, 3815–3830. [Google Scholar] [CrossRef]
- Campbell, A.A.; Song, L.; Li, X.S.; Nelson, B.J.; Bottoni, C.; Brooks, D.E.; DeJong, E.S. Development, characterization, and anti-microbial efficacy of hydroxyapatite-chlorhexidine coatings produced by surface-induced mineralization. J. Biomed. Mater. Res. 2000, 53, 400–407. [Google Scholar] [CrossRef]
- Szałaj, U.; Świderska-Środa, A.; Chodara, A.; Gierlotka, S.; Łojkowski, W. Nanoparticle Size Effect on Water Vapour Adsorption by Hydroxyapatite. Nanomaterials 2019, 9, 1005. [Google Scholar] [CrossRef] [PubMed]
- Tian, B.; Tang, S.; Wang, C.D.; Wang, W.G.; Wu, C.L.; Guo, Y.J.; Guo, Y.P.; Zhu, Z.A. Bactericidal properties and biocompatibility of a gentamicin-loaded Fe3O4/carbonated hydroxyapatite coating. Colloids Surf. B Biointerfaces 2014, 123, 403–412. [Google Scholar] [CrossRef] [PubMed]
- Kolmas, J.; Groszyk, E.; Kwiatkowska-Różycka, D. Substituted Hydroxyapatites with Antibacterial Properties. Biomed. Res. Int. 2014, 2014, 178123. [Google Scholar] [CrossRef] [PubMed]
- Pan, J.; Prabakaran, S.; Rajan, M. In-vivo assessment of minerals substituted hydroxyapatite/poly sorbitol sebacate glutamate (PSSG) composite coating on titanium metal implant for orthopedic implantation. Biomed. Pharmacother. 2019, 119, 109404. [Google Scholar] [CrossRef] [PubMed]
- Kurtz, S.M.; Devine, J.N. PEEK biomaterials in trauma, orthopedic, and spinal implants. Biomaterials 2007, 28, 4845–4869. [Google Scholar] [CrossRef]
- Rabiei, A.; Sandukas, S. Processing and evaluation of bioactive coatings on polymeric implants. J. Biomed. Mater. Res. A 2013, 101, 2621–2629. [Google Scholar] [CrossRef]
- Baştan, F.E.; Rehman, M.A.U.; Avcu, Y.Y.; Avcu, E.; Üstel, F.; Boccaccini, A.R. Electrophoretic co-deposition of PEEK-hydroxyapatite composite coatings for biomedical applications. Colloids Surf. B Biointerfaces 2018, 169, 176–182. [Google Scholar] [CrossRef]
- Masamoto, K.; Fujibayashi, S.; Yabutsuka, T.; Hiruta, T.; Otsuki, B.; Okuzu, Y.; Goto, K.; Shimizu, T.; Shimizu, Y.; Ishizaki, C.; et al. In vivo and in vitro bioactivity of a “precursor of apatite” treatment on polyetheretherketone. Acta Biomater. 2019, 91, 48–59. [Google Scholar] [CrossRef]
- Zhu, C.; He, M.; Mao, L.; Li, T.; Zhang, L.; Liu, L.; Feng, G.; Song, Y. Titanium-interlayer mediated hydroxyapatite coating on polyetheretherketone: A prospective study in patients with single-level cervical degenerative disc disease. J. Transl. Med. 2021, 19, 14. [Google Scholar] [CrossRef]
- Townsend, L.; Williams, R.L.; Anuforom, O.; Berwick, M.R.; Halstead, F.; Hughes, E.; Stamboulis, A.; Oppenheim, B.; Gough, J.; Grover, L.; et al. Antimicrobial peptide coatings for hydroxyapatite: Electrostatic and covalent attachment of antimicrobial peptides to surfaces. J. R. Soc. Interface 2017, 14. [Google Scholar] [CrossRef] [PubMed]
- Yang, C.-C.; Lin, C.-C.; Liao, J.-W.; Yen, S.-K. Vancomycin–chitosan composite deposited on post porous hydroxyapatite coated Ti6Al4V implant for drug controlled release. Mater. Sci. Eng. C 2013, 33, 2203–2212. [Google Scholar] [CrossRef]
- Forsgren, J.; Brohede, U.; Mihranyan, A.; Engqvist, H.; Strømme, M. Fast loading, slow release–a new strategy for incorporating antibiotics to hydroxyapatite. In Proceedings of the Key Engineering Materials; Trans Tech Publications Ltd.: Bäch SZ, Switzerland, 2009; pp. 523–526. [Google Scholar]
- Hussain, S.; Rutledge, L.; Acheson, J.G.; Meenan, B.J.; Boyd, A.R. The Surface Characterisation of Polyetheretherketone (PEEK) Modified via the Direct Sputter Deposition of Calcium Phosphate Thin Films. Coatings 2020, 10, 1088. [Google Scholar] [CrossRef]
- Duta, L.; Neamtu, J.; Melinte, R.P.; Zureigat, O.A.; Popescu-Pelin, G.; Chioibasu, D.; Oktar, F.N.; Popescu, A.C. In Vivo Assessment of Bone Enhancement in the Case of 3D-Printed Implants Functionalized with Lithium-Doped Biological-Derived Hydroxyapatite Coatings: A Preliminary Study on Rabbits. Coatings 2020, 10, 992. [Google Scholar] [CrossRef]
- Wrona, A.; Bilewska, K.; Lis, M.; Kamińska, M.; Olszewski, T.; Pajzderski, P.; Więcław, G.; Jaśkiewicz, M.; Kamysz, W. Antimicrobial properties of protective coatings produced by plasma spraying technique. Surf. Coat. Technol. 2017, 318, 332–340. [Google Scholar] [CrossRef]
- Beddow, J.; Singh, G.; Blanes, M.; Molla, K.; Perelshtein, I.; Gedanken, A.; Joyce, E.; Mason, T. Sonochemical coating of textile fabrics with antibacterial nanoparticles. AIP Conf. Proc. 2012, 1433, 400–403. [Google Scholar] [CrossRef]
- Perelshtein, I.; Lipovsky, A.; Perkas, N.; Tzanov, T.; Gedanken, A. Sonochemical co-deposition of antibacterial nanoparticles and dyes on textiles. Beilstein J. Nanotechnol. 2016, 7, 1–8. [Google Scholar] [CrossRef]
- Svirinovsky, A.; Perelshtein, I.; Natan, M.; Banin, E.; Gedanken, A. Imparting superhydrophobic and biocidal functionalities to a polymeric substrate by the sonochemical method. Ultrason. Sonochem. 2018, 44, 398–403. [Google Scholar] [CrossRef]
- Golda-Cepa, M.; Chytrosz, P.; Chorylek, A.; Kotarba, A. One-step sonochemical fabrication and embedding of gentamicin nanoparticles into parylene C implant coating: Towards controlled drug delivery. Nanomed. Nanotechnol. Biol. Med. 2018, 14, 941–950. [Google Scholar] [CrossRef] [PubMed]
- Woźniak, B.; Szałaj, U.; Chodara, A.; Mizeracki, J.; Łojkowski, M.; Myszka, D.; Łojkowski, W. Mechanism for sonocoating a polymer surface with nano-hydroxyapatite. Mater. Lett. 2019, 249, 155–159. [Google Scholar] [CrossRef]
- Liu, W.J.; Ma, C.Y.; Feng, S.X.; Wang, X.Z. Solubility Measurement and Stability Study of Sodium Cefuroxime. J. Chem. Eng. Data 2014, 59, 807–816. [Google Scholar] [CrossRef]
- Greenwood, D.; Pearson, N.J.; O’Grady, F. Cefuroxime: A new cephalosporin antibiotic with enhanced stability to enterobacterial β-lactamases. J. Antimicrob. Chemother. 1976, 2, 337–343. [Google Scholar] [CrossRef]
- Zhao, L.; Li, Q.; Li, X.; Yin, R.; Chen, X.; Geng, L.; Bi, K. Bioequivalence and population pharmacokinetic modeling of two forms of antibiotic, cefuroxime lysine and cefuroxime sodium, after intravenous infusion in beagle dogs. J. Biomed. Biotechnol. 2012, 2012, 507294. [Google Scholar] [CrossRef] [PubMed][Green Version]
- Racovita, S.; Lungan, M.A.; Bunia, I.; Popa, M.; Vasiliu, S. Adsorption and release studies of cefuroxime sodium from acrylic ion exchange resin microparticles coated with gellan. React. Funct. Polym. 2016, 105, 103–113. [Google Scholar] [CrossRef]
- Gold, B.; Rodriguez, W.J. Cefuroxime: Mechanisms of action, antimicrobial activity, pharmacokinetics, clinical applications, adverse reactions and therapeutic indications. Pharmacotherapy 1983, 3, 82–100. [Google Scholar] [CrossRef]
- Salzmann, G.M.; Naal, F.D.; von Knoch, F.; Tuebel, J.; Gradinger, R.; Imhoff, A.B.; Schauwecker, J. Effects of cefuroxime on human osteoblasts in vitro. J. Biomed. Mater. Res. A 2007, 82, 462–468. [Google Scholar] [CrossRef]
- Lovering, A.M.; Perez, J.; Bowker, K.E.; Reeves, D.S.; MacGowan, A.P.; Bannister, G. A comparison of the penetration of cefuroxime and cephamandole into bone, fat and haematoma fluid in patients undergoing total hip replacement. J. Antimicrob. Chemother. 1997, 40, 99–104. [Google Scholar] [CrossRef] [PubMed][Green Version]
- McQueen, M.M.; Hughes, S.P.F.; May, P.; Verity, L. Cefuroxime in total joint arthroplasty: Intravenous or in bone cement. J. Arthroplast. 1990, 5, 169–172. [Google Scholar] [CrossRef]
- Kuśnieruk, S.; Wojnarowicz, J.; Chodara, A.; Chudoba, T.; Gierlotka, S.; Lojkowski, W. Influence of hydrothermal synthesis parameters on the properties of hydroxyapatite nanoparticles. Beilstein J. Nanotechnol. 2016, 7, 1586–1601. [Google Scholar] [CrossRef]
- Andrzej, M.; Jan, W.; Jan, P.; Tadeusz, C.; Jacek, W. A Novel Reactor for Microwave Hydrothermal Scale-up Nanopowder Synthesis. Int. J. Chem. React. Eng. 2013, 11, 361–368. [Google Scholar] [CrossRef]
- Assaad, H.I.; Zhou, L.; Carroll, R.J.; Wu, G. Rapid publication-ready MS-Word tables for one-way ANOVA. Springerplus 2014, 3, 474. [Google Scholar] [CrossRef]
- Dorozhkin, S.V. Calcium orthophosphate coatings, films and layers. Prog. Biomater. 2012, 1, 1–40. [Google Scholar] [CrossRef]
- Wang, B.C.; Lee, T.M.; Chang, E.; Yang, C.Y. The shear strength and the failure mode of plasma-sprayed hydroxyapatite coating to bone: The effect of coating thickness. J. Biomed. Mater. Res. 1993, 27, 1315–1327. [Google Scholar] [CrossRef] [PubMed]
- Tian, Q.; Lin, J.; Rivera-Castaneda, L.; Tsanhani, A.; Dunn, Z.S.; Rodriguez, A.; Aslani, A.; Liu, H. Nano-to-Submicron Hydroxyapatite Coatings for Magnesium-based Bioresorbable Implants—Deposition, Characterization, Degradation, Mechanical Properties, and Cytocompatibility. Sci. Rep. 2019, 9, 810. [Google Scholar] [CrossRef]
- Jing, W.; Zhang, M.; Jin, L.; Zhao, J.; Gao, Q.; Ren, M.; Fan, Q. Assessment of osteoinduction using a porous hydroxyapatite coating prepared by micro-arc oxidation on a new titanium alloy. Int. J. Surg. 2015, 24, 51–56. [Google Scholar] [CrossRef] [PubMed]
- Son, J.S.; Choi, Y.-A.; Park, E.-K.; Kwon, T.-Y.; Kim, K.-H.; Lee, K.-B. Drug delivery from hydroxyapatite-coated titanium surfaces using biodegradable particle carriers. J. Biomed. Mater. Res. Part B Appl. Biomater. 2013, 101, 247–257. [Google Scholar] [CrossRef] [PubMed]
- Wang, L.; Huang, F.; Wu, Z.; Ma, R. Biocompatibility of nano-hydroxyapatite/polyetheretherketone composite materials with osteoblasts cultured in vitro. AIP Conf. Proc. 2017, 1829, 020004. [Google Scholar] [CrossRef]
- Shuai, C.; Shuai, C.; Wu, P.; Yuan, F.; Feng, P.; Yang, Y.; Guo, W.; Fan, X.; Su, T.; Peng, S.; et al. Characterization and Bioactivity Evaluation of (Polyetheretherketone/Polyglycolicacid)-Hydroyapatite Scaffolds for Tissue Regeneration. Materials 2016, 9, 934. [Google Scholar] [CrossRef]
- Murphy, C.M.; Haugh, M.G.; O’Brien, F.J. The effect of mean pore size on cell attachment, proliferation and migration in collagen–glycosaminoglycan scaffolds for bone tissue engineering. Biomaterials 2010, 31, 461–466. [Google Scholar] [CrossRef]
- Walsh, W.R.; Pelletier, M.H.; Bertollo, N.; Christou, C.; Tan, C. Does PEEK/HA Enhance Bone Formation Compared with PEEK in a Sheep Cervical Fusion Model? Clin. Orthop. Relat. Res. 2016, 474, 2364–2372. [Google Scholar] [CrossRef]
- Tahmasbi Rad, A.; Solati-Hashjin, M.; Osman, N.A.A.; Faghihi, S. Improved bio-physical performance of hydroxyapatite coatings obtained by electrophoretic deposition at dynamic voltage. Ceram. Int. 2014, 40, 12681–12691. [Google Scholar] [CrossRef]
- Jung, U.-W.; Hwang, J.-W.; Choi, D.-Y.; Hu, K.-S.; Kwon, M.-K.; Choi, S.-H.; Kim, H.-J. Surface characteristics of a novel hydroxyapatite-coated dental implant. J. Periodontal Implant Sci. 2012, 42, 59–63. [Google Scholar] [CrossRef] [PubMed]
- Almasi, D.; Lau, W.J.; Rasaee, S.; Sharifi, R.; Mozaffari, H.R. Fabrication of a novel hydroxyapatite/polyether ether ketone surface nanocomposite via friction stir processing for orthopedic and dental applications. Prog. Biomater. 2020, 9, 35–44. [Google Scholar] [CrossRef] [PubMed]
- Eliaz, N.; Shmueli, S.; Shur, I.; Benayahu, D.; Aronov, D.; Rosenman, G. The effect of surface treatment on the surface texture and contact angle of electrochemically deposited hydroxyapatite coating and on its interaction with bone-forming cells. Acta Biomater. 2009, 5, 3178–3191. [Google Scholar] [CrossRef]
- Yu, H.-N.; Hsu, H.-C.; Wu, S.-C.; Hsu, C.-W.; Hsu, S.-K.; Ho, W.-F. Characterization of Nano-Scale Hydroxyapatite Coating Synthesized from Eggshells Through Hydrothermal Reaction on Commercially Pure Titanium. Coatings 2020, 10, 112. [Google Scholar] [CrossRef]
- Zhao, B.; Li, X.; Xu, H.; Jiang, Y.; Wang, D.; Liu, R. Influence of Simvastatin-Strontium-Hydroxyapatite Coated Implant Formed by Micro-Arc Oxidation and Immersion Method on Osteointegration in Osteoporotic Rabbits. Int. J. Nanomed. 2020, 15, 1797–1807. [Google Scholar] [CrossRef] [PubMed]
- Cometa, S.; Bonifacio, M.A.; Ferreira, A.M.; Gentile, P.; De Giglio, E. Surface Characterization of Electro-Assisted Titanium Implants: A Multi-Technique Approach. Materials 2020, 13, 705. [Google Scholar] [CrossRef] [PubMed]
- Li, S.; Yu, W.; Zhang, W.; Zhang, G.; Yu, L.; Lu, E. Evaluation of highly carbonated hydroxyapatite bioceramic implant coatings with hierarchical micro-/nanorod topography optimized for osseointegration. Int. J. Nanomed. 2018, 13, 3643–3659. [Google Scholar] [CrossRef]
- Lotz, E.M.; Olivares-Navarrete, R.; Berner, S.; Boyan, B.D.; Schwartz, Z. Osteogenic response of human MSCs and osteoblasts to hydrophilic and hydrophobic nanostructured titanium implant surfaces. J. Biomed. Mater. Res. A 2016, 104, 3137–3148. [Google Scholar] [CrossRef]
- Ma, R.; Tang, S.; Tan, H.; Qian, J.; Lin, W.; Wang, Y.; Liu, C.; Wei, J.; Tang, T. Preparation, Characterization, In Vitro Bioactivity, and Cellular Responses to a Polyetheretherketone Bioactive Composite Containing Nanocalcium Silicate for Bone Repair. ACS Appl. Mater. Interfaces 2014, 6, 12214–12225. [Google Scholar] [CrossRef]
- AbouAitah, K.; Stefanek, A.; Higazy, I.M.; Janczewska, M.; Swiderska-Sroda, A.; Chodara, A.; Wojnarowicz, J.; Szałaj, U.; Shahein, S.A.; Aboul-Enein, A.M.; et al. Effective Targeting of Colon Cancer Cells with Piperine Natural Anticancer Prodrug Using Functionalized Clusters of Hydroxyapatite Nanoparticles. Pharmaceutics 2020, 12, 70. [Google Scholar] [CrossRef] [PubMed]
- Padmanabhan, V.P.; Kulandaivelu, R.; Santhana Panneer, D.; Vivekananthan, S.; Sagadevan, S.; Anita Lett, J. Microwave synthesis of hydroxyapatite encumbered with ascorbic acid intended for drug leaching studies. Mater. Res. Innov. 2019, 1–8. [Google Scholar] [CrossRef]
- Guillot, R.; Pignot-Paintrand, I.; Lavaud, J.; Decambron, A.; Bourgeois, E.; Josserand, V.; Logeart-Avramoglou, D.; Viguier, E.; Picart, C. Assessment of a polyelectrolyte multilayer film coating loaded with BMP-2 on titanium and PEEK implants in the rabbit femoral condyle. Acta Biomater. 2016, 36, 310–322. [Google Scholar] [CrossRef]
- Min, J.; Choi, K.Y.; Dreaden, E.C.; Padera, R.F.; Braatz, R.D.; Spector, M.; Hammond, P.T. Designer Dual Therapy Nanolayered Implant Coatings Eradicate Biofilms and Accelerate Bone Tissue Repair. ACS Nano 2016, 10, 4441–4450. [Google Scholar] [CrossRef]
- Yaprakci, V.; Erdemli, O.; Kayabolen, A.; Tezcaner, A.; Bozkurt, F.; Keskin, D. In vitro/in vivo comparison of cefuroxime release from poly(ε-caprolactone)-calcium sulfate implants for osteomyelitis treatment. Biotechnol. Appl. Biochem. 2013, 60, 603–616. [Google Scholar] [CrossRef] [PubMed]
- Nandi, S.K.; Kundu, B.; Mukherjee, P.; Mandal, T.K.; Datta, S.; De, D.K.; Basu, D. In vitro and in vivo release of cefuroxime axetil from bioactive glass as an implantable delivery system in experimental osteomyelitis. Ceram. Int. 2009, 35, 3207–3216. [Google Scholar] [CrossRef]
- Niu, X.; Sun, L.; Zhang, X.; Sun, Y.; Wang, J. Fabrication and antibacterial properties of cefuroxime-loaded TiO2 nanotubes. Appl. Microbiol. Biotechnol. 2020, 104, 2947–2955. [Google Scholar] [CrossRef]
- Mäkinen, T.J.; Veiranto, M.; Lankinen, P.; Moritz, N.; Jalava, J.; Törmälä, P.; Aro, H.T. In vitro and in vivo release of ciprofloxacin from osteoconductive bone defect filler. J. Antimicrob. Chemother. 2005, 56, 1063–1068. [Google Scholar] [CrossRef]
- Stevanović, M.; Djošić, M.; Janković, A.; Kojić, V.; Vukašinović-Sekulić, M.; Stojanović, J.; Odović, J.; Crevar Sakač, M.; Kyong Yop, R.; Mišković-Stanković, V. Antibacterial graphene-based hydroxyapatite/chitosan coating with gentamicin for potential applications in bone tissue engineering. J. Biomed. Mater. Res. Part A 2020, 108, 2175–2189. [Google Scholar] [CrossRef]
- Giacomini, D.; Torricelli, P.; Gentilomi, G.A.; Boanini, E.; Gazzano, M.; Bonvicini, F.; Benetti, E.; Soldati, R.; Martelli, G.; Rubini, K.; et al. Monocyclic β-lactams loaded on hydroxyapatite: New biomaterials with enhanced antibacterial activity against resistant strains. Sci. Rep. 2017, 7, 2712. [Google Scholar] [CrossRef]
- Geng, Z.; Cui, Z.; Li, Z.; Zhu, S.; Liang, Y.; Liu, Y.; Li, X.; He, X.; Yu, X.; Wang, R.; et al. Strontium incorporation to optimize the antibacterial and biological characteristics of silver-substituted hydroxyapatite coating. Mater. Sci. Eng. C 2016, 58, 467–477. [Google Scholar] [CrossRef] [PubMed]
- Brohede, U.; Forsgren, J.; Roos, S.; Mihranyan, A.; Engqvist, H.; Strømme, M. Multifunctional implant coatings providing possibilities for fast antibiotics loading with subsequent slow release. J. Mater. Sci Mater. Med. 2009, 20, 1859–1867. [Google Scholar] [CrossRef] [PubMed]

| GoHAP1 1st Coating | GoHAP1 2nd Coating | GoHAP1 3rd Coating | GoHAP1 5th Coating | |
|---|---|---|---|---|
| Thickness of layer (nm) | 218 ± 33 | 368 ± 17 | 462 ± 30 | 478 ± 20 |
| GoHAP3 1st Coating | GoHAP3 2nd Coating | GoHAP3 3rd Coating | GoHAP3 5th Coating | |
| Thickness of layer (nm) | 246 ± 29 | 340 ± 40 | 368 ± 32 | 763 ± 52 |
| Sample Code | PEEK | HAP1 1st Coating | HAP1 2nd Coating | HAP1 3rd Coating | HAP1 5th Coating | HAP3 1st Coating | HAP3 2nd Coating | HAP3 3rd Coating | HAP3 5th Coating |
|---|---|---|---|---|---|---|---|---|---|
| Contact angle | 90° ± 1° | 69° ± 4° | 69° ± 5° | 55° ± 5° | 64° ± 4° | 52° ± 5° | 55° ± 6° | 51° ± 5° | 54° ± 6° |
| GoHAP Type | Mean Drug ± SD (mg/Substrate 1 cm2) |
|---|---|
| PEEK-GoHAP1-Cef | 1.09 ± 0.13 |
| PEEK-GoHAP3-Cef | 0.94 ± 0.16 |
Publisher’s Note: MDPI stays neutral with regard to jurisdictional claims in published maps and institutional affiliations. |
© 2021 by the authors. Licensee MDPI, Basel, Switzerland. This article is an open access article distributed under the terms and conditions of the Creative Commons Attribution (CC BY) license (https://creativecommons.org/licenses/by/4.0/).
Share and Cite
AbouAitah, K.; Bil, M.; Pietrzykowska, E.; Szałaj, U.; Fudala, D.; Woźniak, B.; Nasiłowska, J.; Swiderska-Sroda, A.; Lojkowski, M.; Sokołowska, B.; et al. Drug-Releasing Antibacterial Coating Made from Nano-Hydroxyapatite Using the Sonocoating Method. Nanomaterials 2021, 11, 1690. https://doi.org/10.3390/nano11071690
AbouAitah K, Bil M, Pietrzykowska E, Szałaj U, Fudala D, Woźniak B, Nasiłowska J, Swiderska-Sroda A, Lojkowski M, Sokołowska B, et al. Drug-Releasing Antibacterial Coating Made from Nano-Hydroxyapatite Using the Sonocoating Method. Nanomaterials. 2021; 11(7):1690. https://doi.org/10.3390/nano11071690
Chicago/Turabian StyleAbouAitah, Khaled, Monika Bil, Elzbieta Pietrzykowska, Urszula Szałaj, Damian Fudala, Bartosz Woźniak, Justyna Nasiłowska, Anna Swiderska-Sroda, Maciej Lojkowski, Barbara Sokołowska, and et al. 2021. "Drug-Releasing Antibacterial Coating Made from Nano-Hydroxyapatite Using the Sonocoating Method" Nanomaterials 11, no. 7: 1690. https://doi.org/10.3390/nano11071690
APA StyleAbouAitah, K., Bil, M., Pietrzykowska, E., Szałaj, U., Fudala, D., Woźniak, B., Nasiłowska, J., Swiderska-Sroda, A., Lojkowski, M., Sokołowska, B., Swieszkowski, W., & Lojkowski, W. (2021). Drug-Releasing Antibacterial Coating Made from Nano-Hydroxyapatite Using the Sonocoating Method. Nanomaterials, 11(7), 1690. https://doi.org/10.3390/nano11071690

